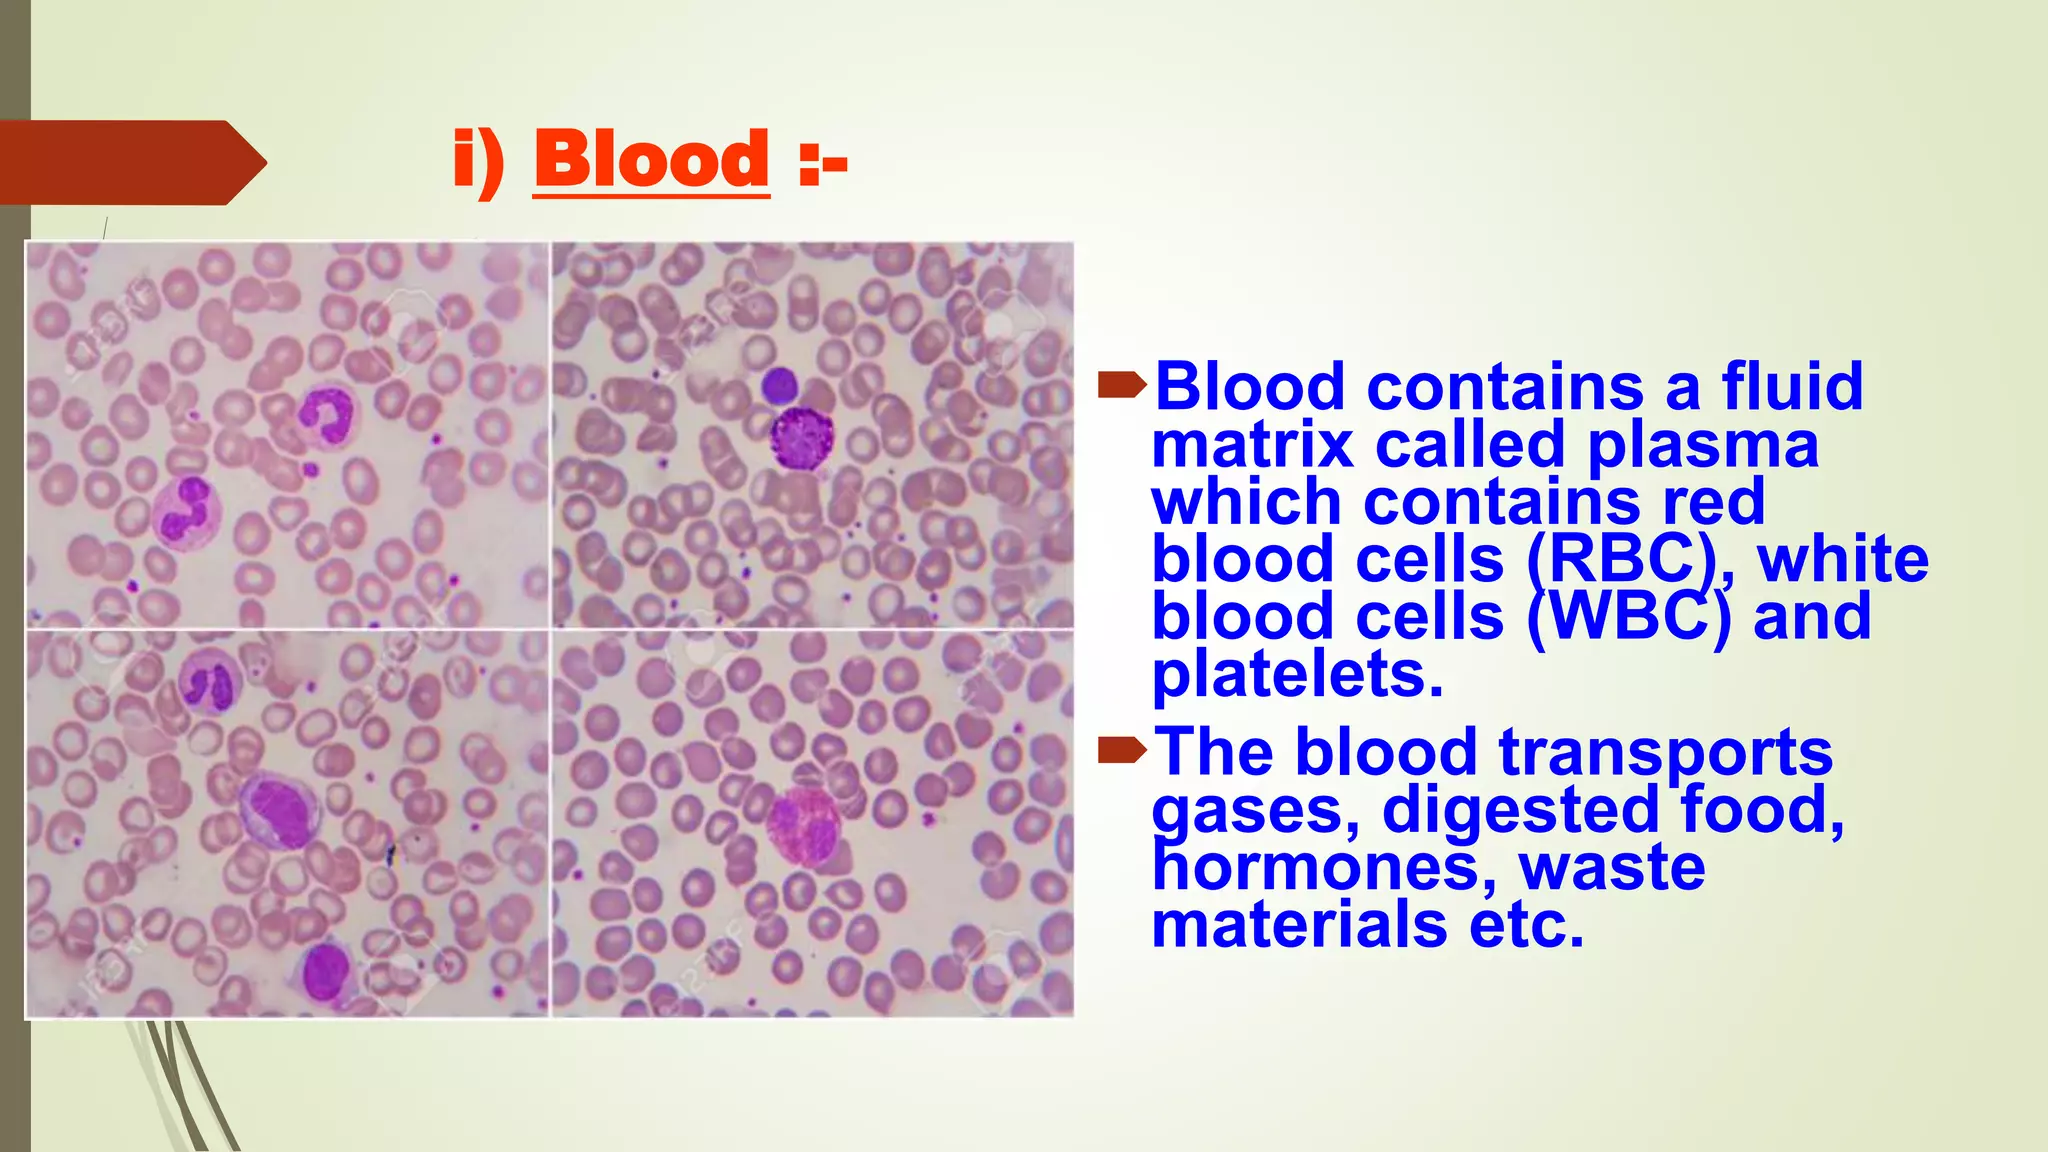
i) Blood :-
Blood contains a fluid
matrix called plasma
which contains red
blood cells (RBC), white
blood cells (WBC) and
platelets.
The blood transports
gases, digested food,
hormones, waste
materials etc.

Tissues are groups of cells that work together to perform specific functions. There are four main types of animal tissues - epithelial, muscular, connective, and nervous tissue. Epithelial tissue forms protective layers like skin and lines body cavities. It consists of closely packed cells with little extracellular space. Plant tissues include meristematic tissue for growth and permanent tissues like parenchyma, collenchyma, and sclerenchyma. Vascular tissues xylem and phloem transport water and nutrients throughout the plant. Tissues are made of groups of cells that carry out important roles in living organisms.